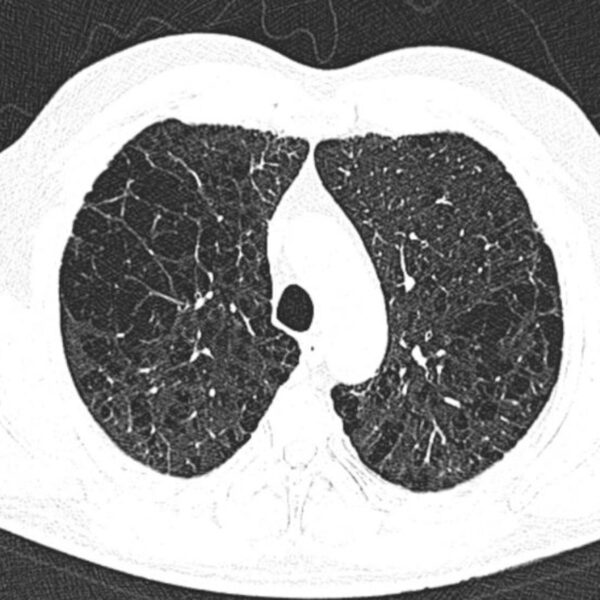

CT
Showing 145–153 of 164 results
-

Case 46CT
0 $ Add to cart -

Case 47CT
0 $ Add to cart -

Case 49CT
0 $ Add to cart -

Case 53CT
0 $ Add to cart -

Case 60CT
0 $ Add to cart -

Case 64CT
0 $ Add to cart -

Case 66CT
0 $ Add to cart -

Case 69CT
0 $ Add to cart -

Case 7CT
0 $ Add to cart
"" has been added to your cart.View cart